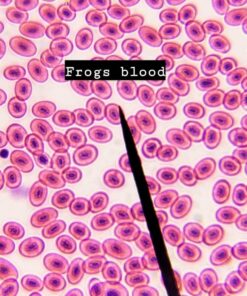
AmScope M162C-2L-PB10-WM-SP14-50P100S 40X-1000X Beginners Microscope Kit for Kids & Students w/Complete Science Accessory Kit + World of The Microscope Book 80 81MV4y0Qj0L

AmScope M162C-2L-PB10-WM-SP14-50P100S 40X-1000X Beginners Microscope Kit for Kids & Students w/Complete Science Accessory Kit + World of The Microscope Book
Description
Features:
- Optical glass monocular microscope with top & bottom LED lights
- 40X-1000X Five wide field magnifications
- Sturdy metal frame with coaxial coarse & fine focusing
- Single Lens Condenser and 6-Hole Disc Diaphragm
- Compatible with 110V power adapter or AA batteries.
Product Details:
- Light Source Type: LED
- Material: Metal
- Color: Blue,Red
- Product Dimensions: 16"L x 12"W x 8"H
- Real Angle of View: 45 Degrees
- Magnification Maximum: 1000 x
- Voltage: 110 Volts
- Brand: AmScope
- Objective Lens Description: Achromatic
- Power Source: Battery Powered
- Package Dimensions: 14.33 x 8.94 x 6.85 inches
- Item Weight: 5.77 pounds
- Item model number: M162C-2L-PB10-WM-SP14-50P100S
- Batteries: 3 AA batteries required.
- Is Discontinued By Manufacturer: No
- Date First Available: March 3, 2011
- Manufacturer: AmScope
- Country of Origin: China

Minecraft 7 Plush Enderman & Creeper Set Of 2
Faerie Tale Theatre - Complete Series DVD
July 1, 2016